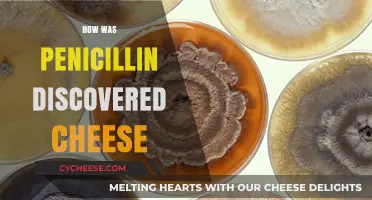
Cheese, Mold, and Medicine: The Serendipitous Discovery of Penicillin

Cheese, a staple in cuisines worldwide, is believed to have been discovered accidentally thousands of years ago. The most widely accepted theory suggests that its origins trace back to ancient nomadic herders in the Middle East, who stored milk in containers made from the stomachs of animals. These stomachs contained rennet, a natural enzyme that, combined with the warmth of the environment, caused the milk to curdle and separate into curds and whey. This unintended transformation preserved the milk in a more durable form, leading to the creation of one of humanity’s most beloved foods. Over time, this accidental discovery evolved into the diverse and sophisticated art of cheesemaking we know today.
| Characteristics | Values |
|---|---|
| Origin | Cheese was likely discovered accidentally in the Middle East around 8000 BCE. |
| Method of Discovery | Milk stored in containers made from the stomachs of animals (e.g., sheep, goats) curdled due to the presence of rennet, an enzyme in the stomach lining. |
| Role of Rennet | Rennet caused the milk to coagulate, separating into curds (solid) and whey (liquid). |
| Environmental Factors | Warm temperatures in the region facilitated the natural fermentation process. |
| Early Use | The curds were likely pressed and salted, creating a primitive form of cheese. |
| Historical Evidence | Archaeological findings suggest cheese-making dates back to 5500 BCE in Poland, with strainers and sieves used for curdling milk. |
| Cultural Spread | Cheese-making techniques spread across Europe, Asia, and beyond through trade and migration. |
| Modern Variations | Thousands of cheese varieties exist today, each with unique flavors, textures, and production methods. |
| Significance | The accidental discovery of cheese revolutionized food preservation and became a staple in many cultures. |
Explore related products
What You'll Learn
- Milk Storage in Animal Stomachs: Early humans stored milk in containers made from animal stomachs, which contained rennet
- Natural Fermentation Process: Milk left in warm environments naturally curdled due to bacteria and enzymes
- Salt as Preservative: Adding salt to milk caused separation into curds and whey, creating cheese
- Accidental Curdling: Milk spilled or mixed with acidic substances like fruit juices curdled unexpectedly
- Observation of Animals: Noticing milk curdling in animal stomachs led to intentional cheese-making experiments

Milk Storage in Animal Stomachs: Early humans stored milk in containers made from animal stomachs, which contained rennet
The practice of storing milk in animal stomachs was a pivotal step in the accidental discovery of cheese. Early humans, seeking ways to preserve milk, turned to nature’s own containers: the stomachs of animals like goats or sheep. These stomachs, still containing traces of rennet—an enzyme complex found in the lining of ruminant animals’ fourth stomach chamber—acted as natural coagulants. When milk was stored in these containers, the rennet caused it to curdle, separating into solid curds and liquid whey. This unintended transformation laid the foundation for one of humanity’s most enduring foods.
To replicate this ancient method, one would begin by cleaning and preparing an animal stomach, ensuring it retains its natural rennet. Fresh milk, ideally unpasteurized to allow for enzymatic activity, is then poured into the stomach and sealed. Over time—typically 24 to 48 hours, depending on temperature and rennet concentration—the milk curdles. The curds can be strained, pressed, and salted to create a rudimentary cheese. This process highlights the ingenuity of early humans, who turned a simple storage solution into a culinary breakthrough.
Comparatively, modern cheese-making relies on purified rennet or microbial coagulants, but the principle remains the same. The animal stomach method, though less precise, offers a tangible connection to our ancestors’ resourcefulness. It also underscores the role of serendipity in culinary history: what began as a practical solution for milk preservation evolved into a global food phenomenon. This approach serves as a reminder that innovation often arises from necessity and observation.
For those interested in experimenting with this ancient technique, caution is advised. Ensure the animal stomach is sourced hygienically and handled safely to avoid contamination. Modern adaptations might involve using a clean, food-grade container lined with commercially available rennet to mimic the enzymatic reaction. While the results may differ from contemporary cheeses, the process provides a hands-on understanding of how cheese was likely discovered. This method is not just a historical curiosity but a testament to the transformative power of simple, natural processes.
Fixing Rubbery Cheese: Simple Tips to Restore Its Creamy Texture
You may want to see also

Natural Fermentation Process: Milk left in warm environments naturally curdled due to bacteria and enzymes
Milk, when left in warm environments, undergoes a natural transformation that has captivated human curiosity for millennia. This process, driven by bacteria and enzymes, is the foundation of cheese-making. Imagine ancient herders storing milk in animal stomachs, only to discover it had thickened and soured into a solid mass—a happy accident that birthed one of humanity’s most cherished foods.
The Science Behind the Curdle
Warm temperatures accelerate the activity of naturally occurring lactic acid bacteria in milk. These bacteria ferment lactose, producing lactic acid, which lowers the milk’s pH. Simultaneously, enzymes like rennet (often present in animal stomach linings) or microbial transglutaminase break down proteins, causing the milk to curdle. This dual action—acidification and coagulation—separates milk into curds (solid) and whey (liquid), the first step in cheese production.
Practical Tips for Recreating the Process
To observe this phenomenon, leave raw milk (unpasteurized, as pasteurization kills essential bacteria) in a warm (75–85°F or 24–29°C) environment for 12–24 hours. Stir occasionally to distribute bacteria evenly. For a faster result, add a tablespoon of cultured buttermilk per cup of milk to introduce active bacteria. Once curds form, strain them through cheesecloth, reserving the whey for other uses like bread-making or animal feed.
Cautions and Considerations
While natural fermentation is fascinating, it’s not without risks. Raw milk can harbor pathogens like *E. coli* or *Salmonella*, so ensure it’s from a trusted source. If using pasteurized milk, inoculate it with a starter culture to mimic the bacterial activity. Avoid temperatures above 90°F (32°C), as this can kill beneficial bacteria or promote harmful ones. Always refrigerate the curds promptly to prevent spoilage.
The Takeaway
This accidental discovery highlights humanity’s ingenuity in harnessing natural processes. By understanding the interplay of bacteria, enzymes, and temperature, we’ve transformed a simple curdle into a global culinary art. Whether you’re a curious home cook or a cheese enthusiast, experimenting with natural fermentation offers a tangible connection to our ancestors’ resourcefulness—and a delicious reward.
Mastering the Undertale Final Boss: Easy Cheese Strategies Revealed
You may want to see also

Salt as Preservative: Adding salt to milk caused separation into curds and whey, creating cheese
The accidental discovery of cheese likely began with a simple act of preservation. Early humans, seeking to extend the shelf life of milk, turned to salt—a prized commodity for its ability to inhibit bacterial growth. Adding salt to milk, however, triggered an unexpected transformation. The milk separated into solid curds and liquid whey, a process that laid the foundation for one of the world’s most beloved foods. This serendipitous reaction was not just a culinary breakthrough but a survival mechanism, allowing communities to store nutrients from milk long after it would have otherwise spoiled.
To replicate this ancient discovery, start with fresh milk and a measured amount of salt. For every liter of milk, add 1–2 teaspoons of non-iodized salt (iodized salt can affect flavor and texture). Stir gently and observe as the milk begins to curdle within minutes. The curds, rich in protein and fat, will rise to the top, while the whey, a nutrient-dense liquid, settles below. This separation is the first step in cheese-making, a process that can be further refined by heating, pressing, and aging. Practical tip: Use a thermometer to monitor the milk’s temperature, as heat accelerates curdling but must be controlled to avoid overcooking.
Comparing this method to modern cheese-making highlights both its simplicity and ingenuity. Today, rennet or acidic agents like vinegar are commonly used to coagulate milk, but salt remains a key player in certain traditional recipes, such as halloumi or feta. The salt-induced curdling method is particularly effective in warm climates where milk spoils quickly, making it a likely candidate for cheese’s origins in regions like the Middle East or Central Asia. This technique not only preserved milk but also concentrated its nutrients, providing a calorie-dense food source for nomadic and agrarian societies alike.
The takeaway is clear: salt’s role in cheese’s accidental discovery was twofold. It preserved milk and, in doing so, unlocked a chemical reaction that transformed it into a new food entirely. For those experimenting with homemade cheese, understanding this process offers a deeper appreciation for the craft. Start with small batches, adjust salt levels to taste, and embrace the imperfections that come with trial and error. After all, the first cheese was likely far from perfect, but it paved the way for the thousands of varieties we enjoy today.
Discover the Cheesy Delight: Ingredients on Domino's 6 Cheese Pizza
You may want to see also
Explore related products

Accidental Curdling: Milk spilled or mixed with acidic substances like fruit juices curdled unexpectedly
Milk, when exposed to acidic substances, undergoes a fascinating transformation: it curdles. This simple chemical reaction, often accidental, is believed to be the ancient precursor to cheese-making. Imagine a nomadic herder carrying milk in a pouch made from an animal stomach. The rennet, a natural enzyme in the stomach lining, would have mixed with the milk, causing it to separate into curds and whey. Similarly, a spill of milk into a container holding acidic fruit juices—like lemon or pomegranate—could have yielded the same result. These unintended curdling incidents likely sparked curiosity, leading to deliberate experimentation and the eventual mastery of cheese production.
To replicate this accidental discovery at home, try a simple experiment. Pour 2 cups of whole milk into a saucepan and heat it to 180°F (82°C), stirring occasionally. Remove from heat and add 2 tablespoons of fresh lemon juice or vinegar, stirring gently for 10 seconds. Within minutes, the milk will curdle, forming soft curds. Strain the mixture through a cheesecloth to separate the curds from the whey. This basic process mirrors the serendipitous curdling that may have occurred in ancient times, offering a tangible connection to the origins of cheese.
While accidental curdling is intriguing, it’s important to note the role of acidity levels. A pH drop below 4.6 is typically required to curdle milk effectively. For instance, lemon juice has a pH of around 2, making it a potent curdling agent. However, not all acidic substances yield the same results. Mild acids like orange juice (pH 3.5) may curdle milk but produce a less cohesive curd. Experimenting with different acids can reveal how early cheese-makers might have tested various natural ingredients to refine their techniques.
The takeaway from accidental curdling is its dual nature: both a nuisance and a revelation. Spilled milk mixed with acidic substances could have been seen as a waste, yet it also presented an opportunity. This duality underscores the ingenuity of early humans, who turned mishaps into milestones. By observing and replicating these accidental processes, we not only gain insight into cheese’s origins but also appreciate the simplicity behind one of humanity’s most enduring foods.
Slicing Secrets: How Many Cheese Slices in a Pound?
You may want to see also

Observation of Animals: Noticing milk curdling in animal stomachs led to intentional cheese-making experiments
The ancient practice of cheese-making likely began with a simple yet profound observation: milk stored in animal stomachs would often curdle and solidify. Early herders, particularly in the Fertile Crescent and Central Asia around 8000 BCE, noticed this transformation as they carried milk in containers made from the stomachs of ruminants like goats and sheep. The rennet, an enzyme present in the lining of these stomachs, naturally coagulated the milk, separating it into curds and whey. This accidental discovery sparked curiosity, leading to intentional experiments with milk, heat, and enzymes to replicate the process.
To recreate this early cheese-making method, one could follow a simplified version of the process. Start by obtaining fresh, unpasteurized milk and a piece of a ruminant stomach lining (or modern rennet tablets as a substitute). Place the milk in a container and add a small amount of rennet—typically 1-2 drops per liter of milk. Allow the mixture to sit at room temperature (around 20-25°C) for 12-24 hours, observing how the milk thickens and separates into curds and whey. This hands-on approach provides insight into the trial-and-error methods early humans likely employed to refine cheese-making techniques.
Comparing this ancient practice to modern cheese production highlights both continuity and innovation. While today’s methods involve precise temperature controls, microbial cultures, and industrial equipment, the core principle remains the same: curdling milk to create a solid, edible product. The observation of animals and their digestive processes laid the foundation for a global culinary tradition. For instance, the use of rennet in traditional cheeses like Pecorino Romano directly links back to these early discoveries, while vegetarian alternatives like microbial rennet showcase how humanity builds on ancient knowledge.
Persuasively, this animal-inspired origin story underscores the importance of observation and experimentation in human innovation. By paying attention to the natural world, early humans transformed a chance occurrence into a sustainable food source. Modern enthusiasts can draw inspiration from this history, embracing curiosity and resourcefulness in their own culinary explorations. Whether making cheese at home or appreciating its rich heritage, understanding this origin story deepens our connection to both food and history.
Cheese's Global Appeal: Exploring Its Universal Popularity and Cultural Impact
You may want to see also
Frequently asked questions
Cheese is believed to have been discovered accidentally around 8000 years ago when milk stored in containers made from animal stomachs curdled due to the presence of rennet, an enzyme that coagulates milk.
There is no single person credited with the discovery of cheese; it is thought to have been an accidental invention by early humans in the Middle East who stored milk in animal stomachs.
Animal stomachs, particularly those of ruminants like sheep and goats, contain rennet, an enzyme that causes milk to curdle. When milk was stored in these stomachs, it separated into curds and whey, creating an early form of cheese.
The discovery was completely by chance. Early humans likely observed the transformation of milk into a solid form when stored in animal stomachs and later refined the process intentionally.






![Origin [DVD]](https://m.media-amazon.com/images/I/81-zv53RjKL._AC_UY218_.jpg)




![Origin [Blu-Ray]](https://m.media-amazon.com/images/I/71PG9yYQLpL._AC_UY218_.jpg)